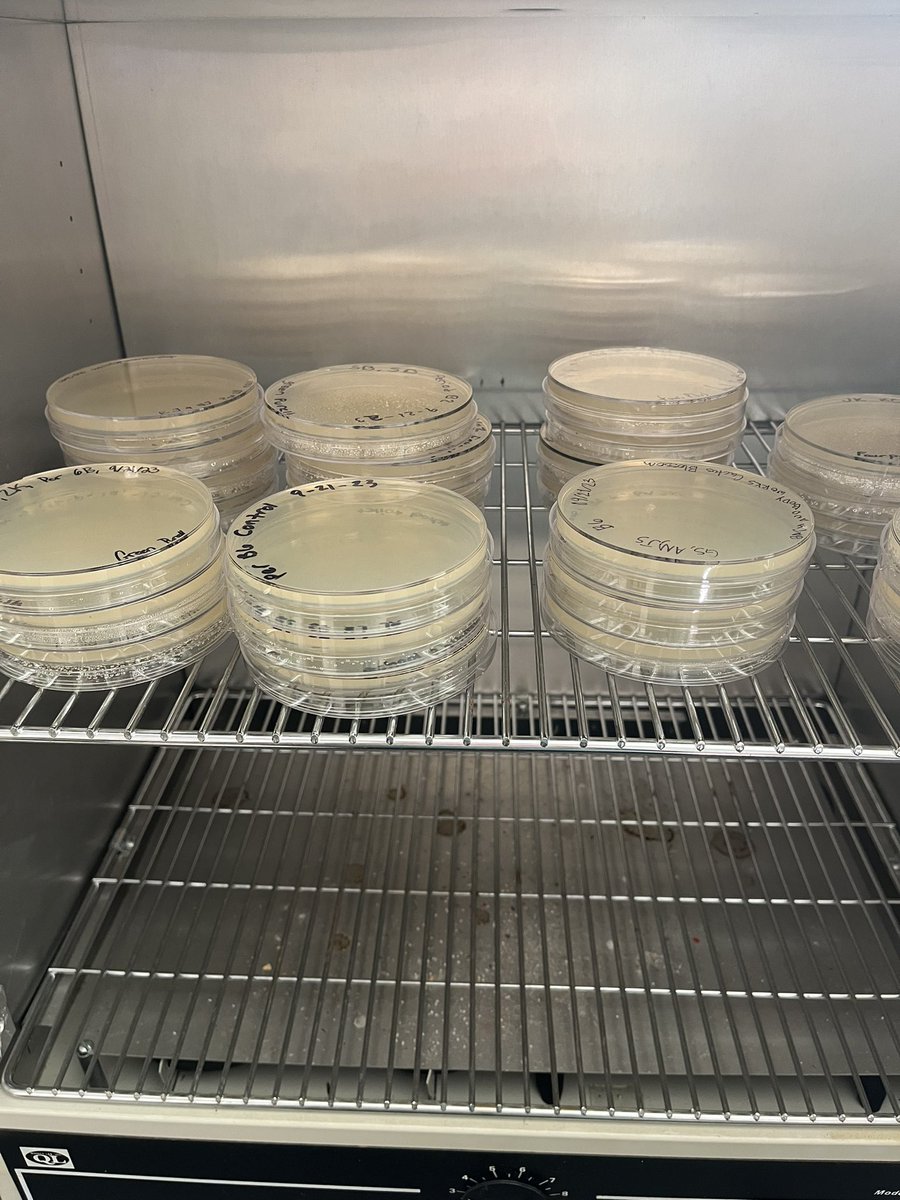
Melissa Bryant tweet media

The Genetics class completed their first PCR today! They will ultimately determine their own genotypes for the ACE gene 🧬 Thanks to @jacksonlab Teaching the Genome Generation (TtGG) for partnering with us to introduce students to really cool molecular biology labs! #TGSNATION


English